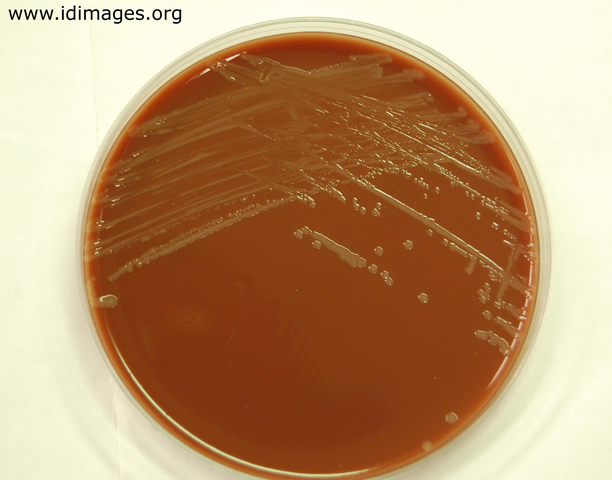
Haemophilus influenzae
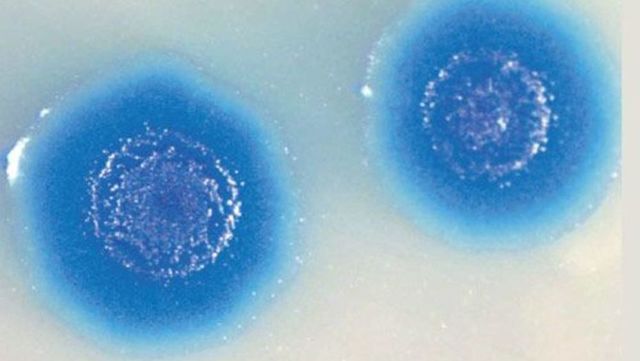
Celera Genomics

-
descubre la nucleina
-
por primera vez denomina a la nucleina como ácidos nucleicos.
-
Identifica los componentes de los ácidos nucleicos, como los azucares y las bases nitrogenadas
-
Descubren que el ADN era un polímero
-
Extrajo ADN puro de plantas y demuestra que estas tienen los dos tipos de ácidos nucleicos
-
Es el encargado de determinar que el ADN jugaba un papel importante en la herencia
-
Analizó el ADN de diferentes especies y determinó su composición de bases A, T, C y G. Pudo concluir que la cantidad de A siempre era igual a la cantidad de T y la cantidad de C siempre era igual a la cantidad de G (A = T y G = C)
-
Realizaron una serie de experimentos para confirmar que el ADN es la base del material genético y no las proteínas, teoría que pusieron a prueba en lo que se denominó el experimento de Hershey y Chase
-
Descubrimiento de la hélice α y la hoja β como componentes estructurales d ellas proteínas.
-
Descubrieron la famosa estructura de doble hélice o escalera en espiral, modelo del ADN que conocemos y manejamos en la actualidad.
-
las imágenes por difracción de rayos X que revelaron la forma de doble hélice de esta molécula son de su autoría. la famosa fotografía 51.
-
Dedicado al estudio de la estructura de las proteínas y sus aminoácidos de la molécula de la insulina
-
descubrieron la polinucleótido fosforilasa, enzima que se convirtió en una herramienta fundamental para el desciframiento del código genético y la síntesis in vitro del ARN.
-
demostraron que la replicación de ADN era semiconservadora. Una replicación semiconservadora es aquella en que la cadena de dos filamentos en hélice del ADN se replica de forma tal que cada una de las dos cadenas de ADN formadas consisten en un filamento proveniente de la hélice original y un filamento nuevo sintetizado.
-
Descubren que la molécula de ARNt funciona como adaptador, concepto o hipótesis propuesta por Franancis Crick ese mismo año.
-
Logró obtener miligramos de una enzima que él denominó ADN polimerasa; ésta era capaz de sintetizar una nueva cadena de ADN a partir de una cadena existente y empleando nucleótidos trifosfato
-
Se da el descubrimiento de la ARN polimerasa
-
Estudiaron de la estructura de las proteínas de los glóbulos rojos (hemoglobina), realizando también investigaciones sobre la proteína muscular denominada mioglobina.
-
Regulación genética de la síntesis de enzimas y virus y planteamiento del concepto de ARNm.
-
desarrollo de la técnica de hibridación de ácidos nucleicos
-
El modelo operon, el ADN procariota se organiza en paquetes coherentes denominados OPERONES, en los cuales se encuentran los genes para funciones interrelacionadas.
-
Lograron romper por primera vez el código genético de los seres vivos y a su vez el desciframiento del mismo.
-
Ganador del premio nobel gracias a describir la estructura de la valina en el ARNt.
-
Junto a sus colaboradores estudiaron la estructura por difracción de rayos X de la lisozima de la CHG y sus características y encontraron que la molécula de proteína tiene una forma casi elipsoidal y mide 30x30x45.
-
Propuso que la base 5’ del anticodón (aquella que se aparea con la posición 3’ del codón) era capaz de titubear (fluctuar) con lo que podían formarse puentes de hidrógeno alternativos entre G y U (algo bastante frecuente en los RNA).
-
Demuestran la existencia de secuencias señal y genes receptores para estas secuencias.
-
Consigue la síntesis artificial de una enzima ribonucleasa.
-
hicieron el descubrimiento de las proteínas de restricción.
-
utilizaron las enzimas de restricción y ligasas de ADN como “ tijeras y pegamento” moleculares para así crear la primera molécula recombinante de ADN, gracias al uso del virus SV40 y del bacteriófago lambda. Fueron los primeros en realizar la primera clonación exitosa.
-
Demostraron que el gen para el ADN recambinante podía ser trasferido y expresado en una célula bacteriana. Desarrollaron un método de transformación de la química celular para Escherichia coli.
-
primera patente en EEUU de una técnica para realizar recombinación genética
-
Desarrollaron un método para secuenciar ADN basado en la modificación química del ADN y posterior escisión en bases específicas
-
El método de secuenciación por dideoxinucleótidos, más conocido como el método Sanger se basa en el proceso biológico de la replicación del ADN.
-
Creador de la técnica Southern Blot, esta técnica de hibridación que permite identificar fragmentos de ADN separados por electroforesis en gel y transferidos a una membrana de nitrocelulosa o nylon.
-
fundadores Genentech Incorporated, la primera empresa de ingeniería genética.
-
Descubre los RFLP, es decir polimorfismos en la longitud de los fragmentos de restricción, esto se refiere a secuencias específicas de nucleótidos en el ADN que son reconocidas y cortadas por las enzimas de restricción (también llamadas endonucleasas de restricción) y que varían entre individuos.
-
-
Autor de la técnica de reacción en cadena de la polimerasa (PCR), la cual permite replicar genes específicos.
-
-
Crearon ratones gigantes por medio de ingeniería genética, lo que se denominó ¨superratón¨.
-
Esto se logró por infección de la bacteria del suelo Agrobacterium tumefaciens que introduce un gen de su plásmido en las células de la planta infectada, provocándole un tumor o agalla
-
Es una técnica que se utiliza para distinguir entre los individuos de una misma especie utilizando muestras de su ADN
-
-
Crea el primer secuenciador automatizado
-
Su objetivo principal es conocer la secuencia completa del genoma humano
-
Describió por primera vez los vectores de clonación y se crea el cromosoma artificial de levaduras o YAC (Yeast artificial chromosome)
-
De la mano a este hecho se puede decir que inicia la era de la bioinformatica.
-
Esta organización se crea con el fin de llevar a cabo el proyecto del genoma humano anteriormente propuesto.
-
Descubrió junto a su equipo los marcadores de secuencia expresada EST (expressed sequence tag), son pequeñas subsecuencias de una secuencia nucleotídica transcrita (codificante de una proteína o no). Se pueden usar para identificar genes que se transcriben y en el descubrimiento de genes, y para determinación de secuencias.
-
Divulgaron datos relativos a un proceso de clonación de células humanas, mediante un experimento de escisión gemelar (splitting) de embriones humanos de 2, 4 y 8 embrioblastos.
-
se publica la se ciencia de este organismo, el cual es el primero.
-
Se completa la secuencia de estos genomas.
-
Primer mamífero en ser clonado de una célula adulta, es de sobra el clon más famoso del mundo. No obstante, la clonación ha existido en la naturaleza desde los albores de la vida
-
Se completa la secuencia de este genoma.
-
-
Publicación de la secuencia de esta especie
-
Publicación de la secuencia completa de este tipo de planta.
-
-
-
-
-
Contruyeron la primera célula artificial.
A list shows items. A timeline shows sequence.
Use Timetoast to make dates, milestones, and turning points easier to understand in a clear visual format. Timetoast is a timeline maker for work, school, research, and stories.